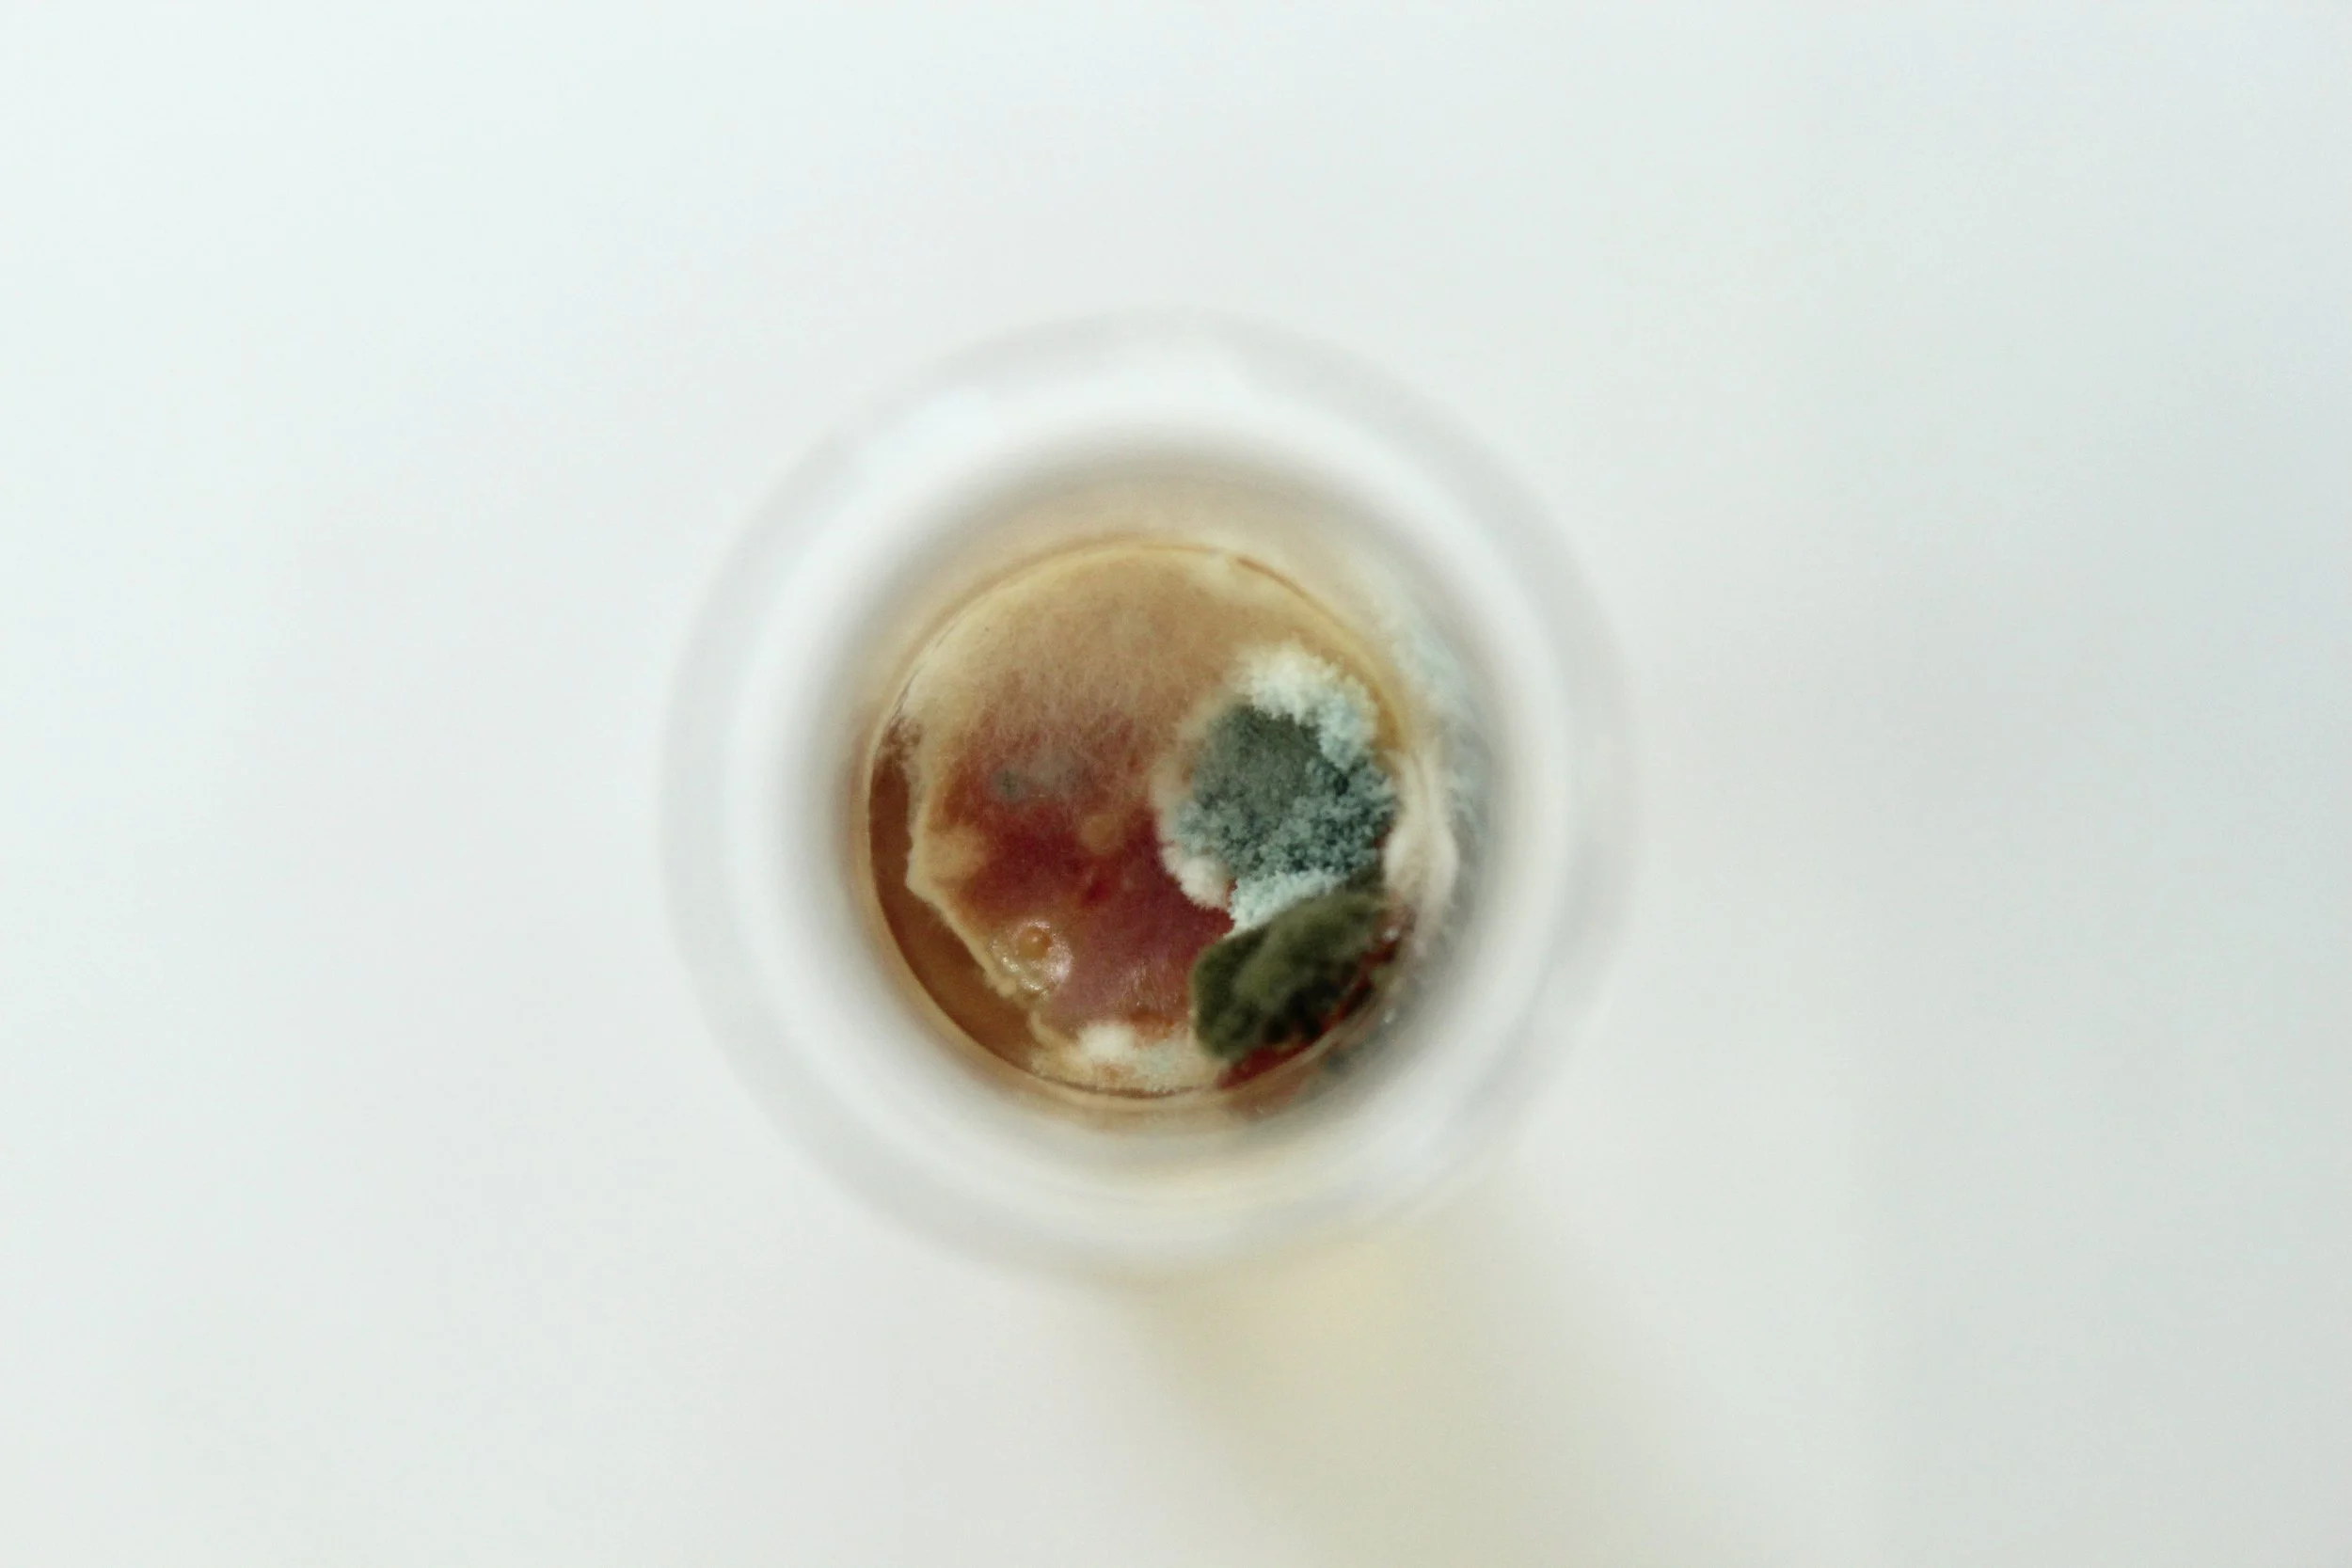
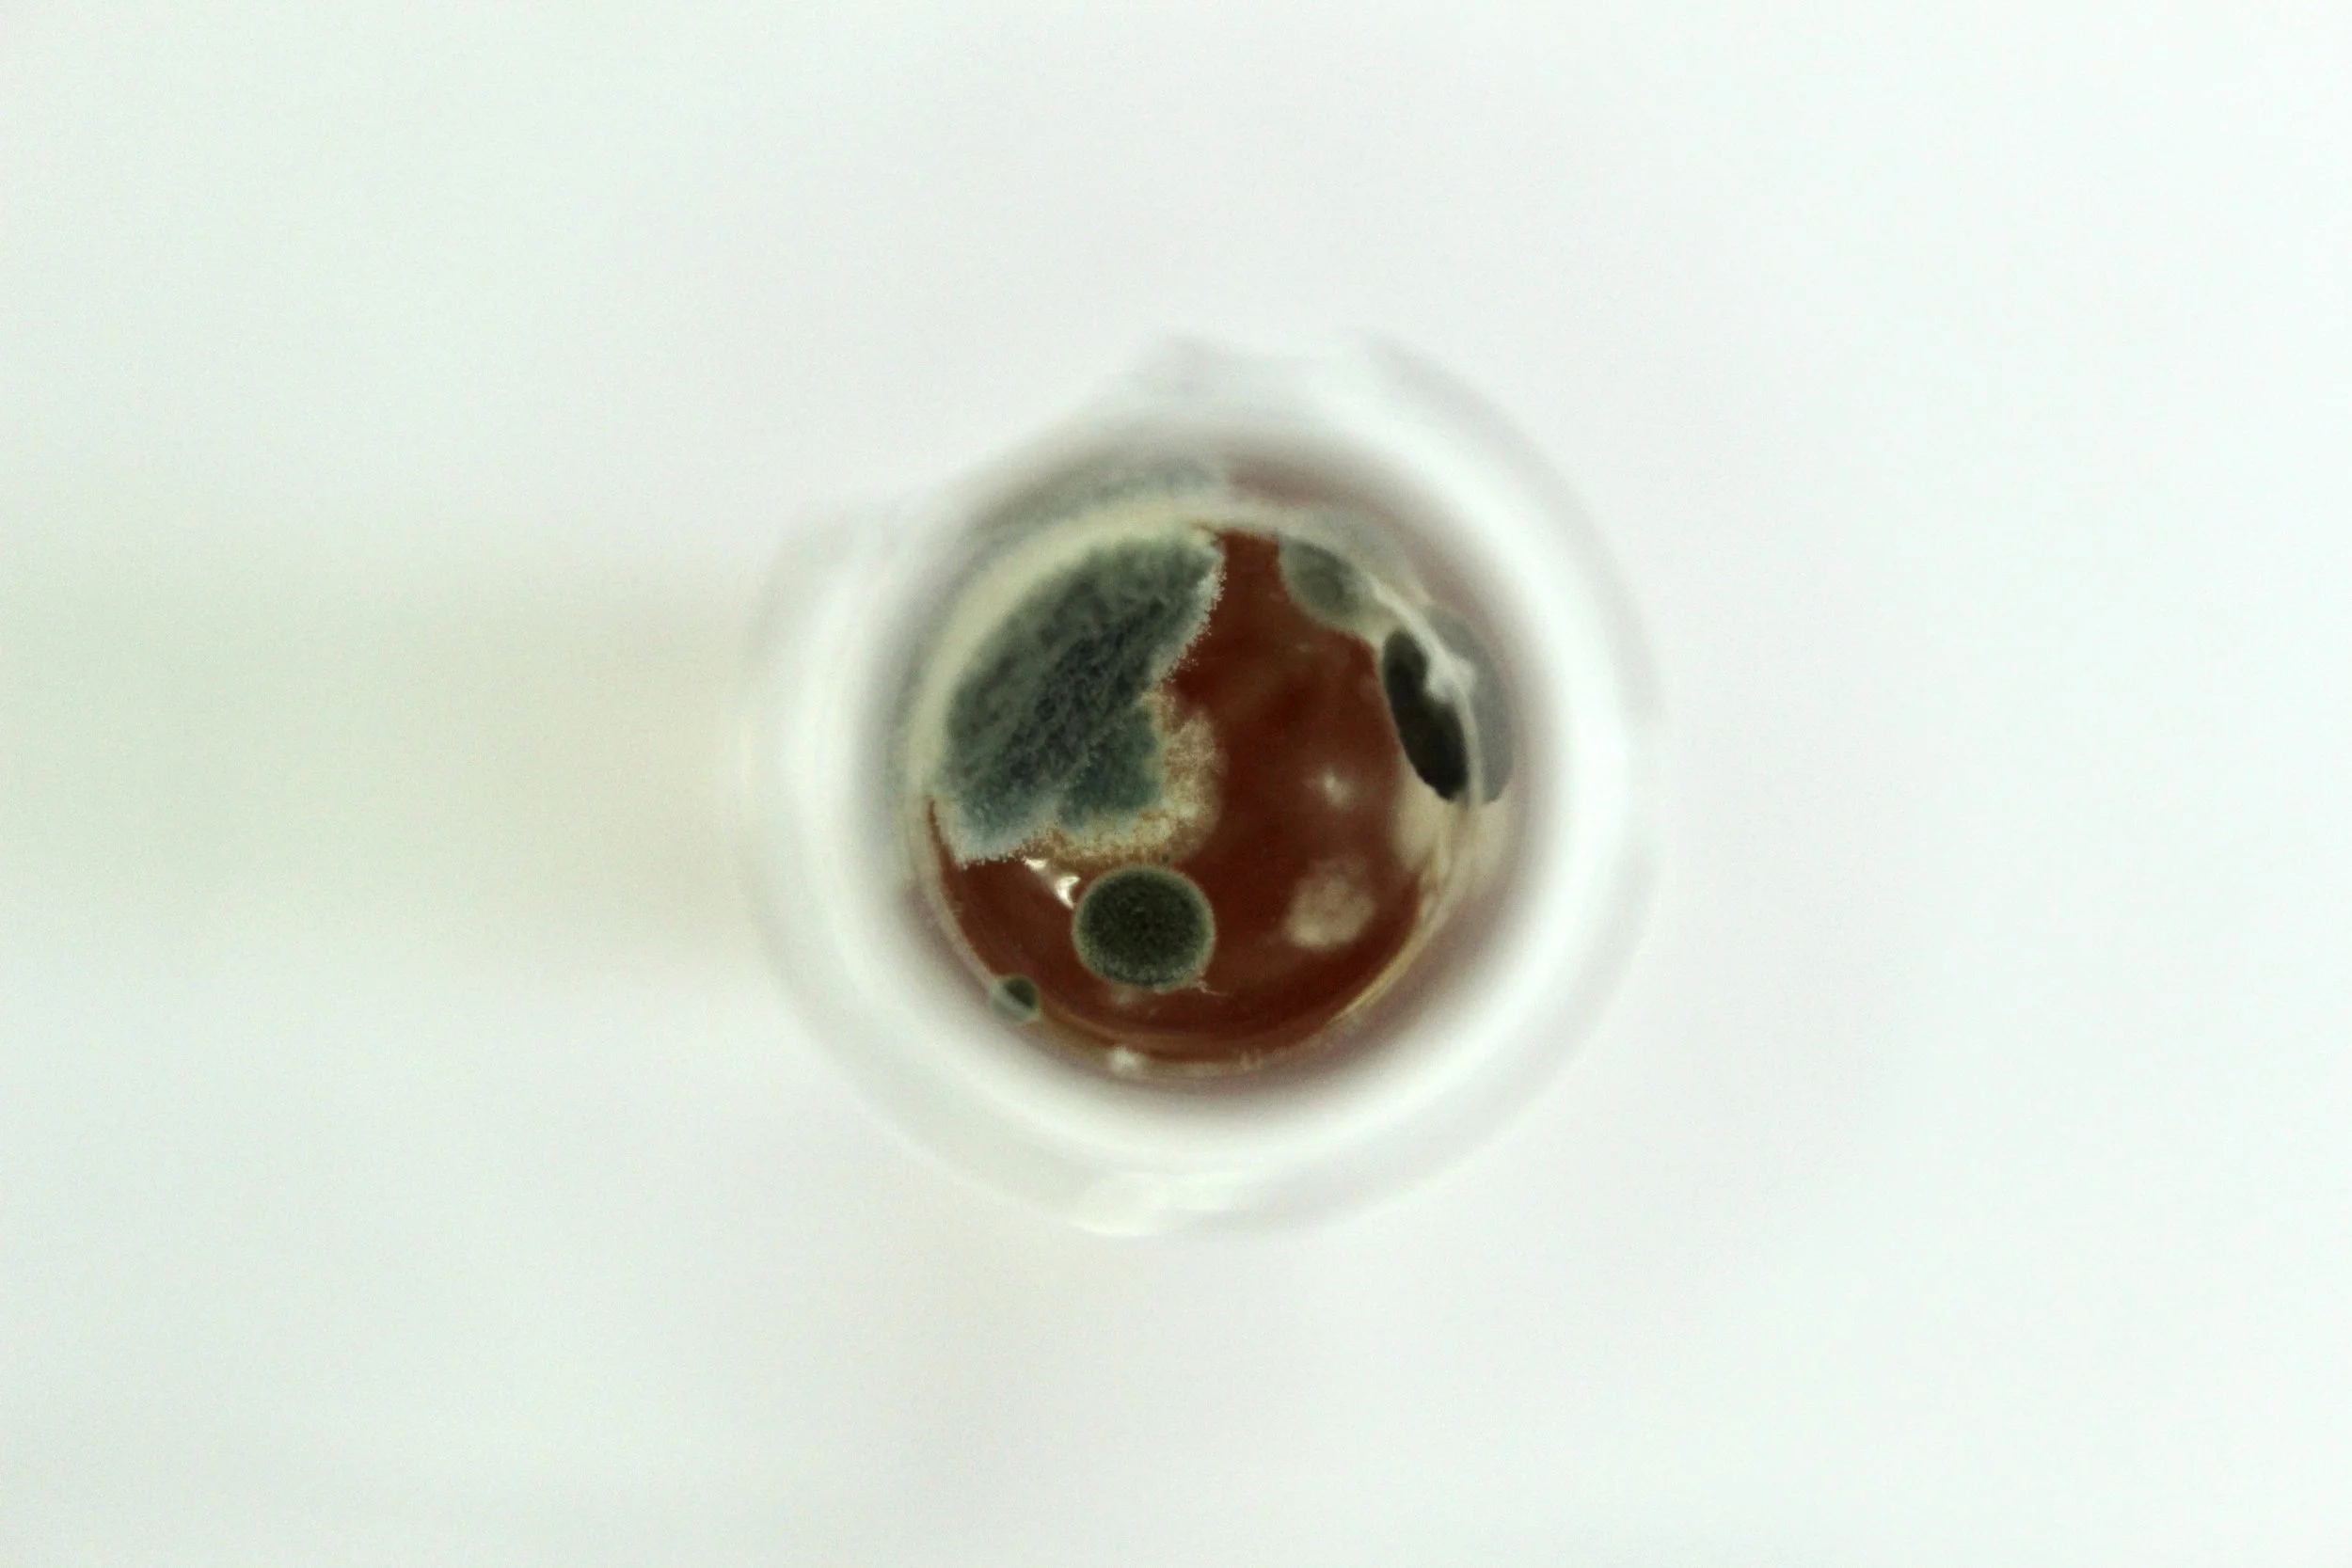

Piss Microcosms I
(22/02/23)
Digital photographic series.




























(22/02/23)
Digital photographic series.